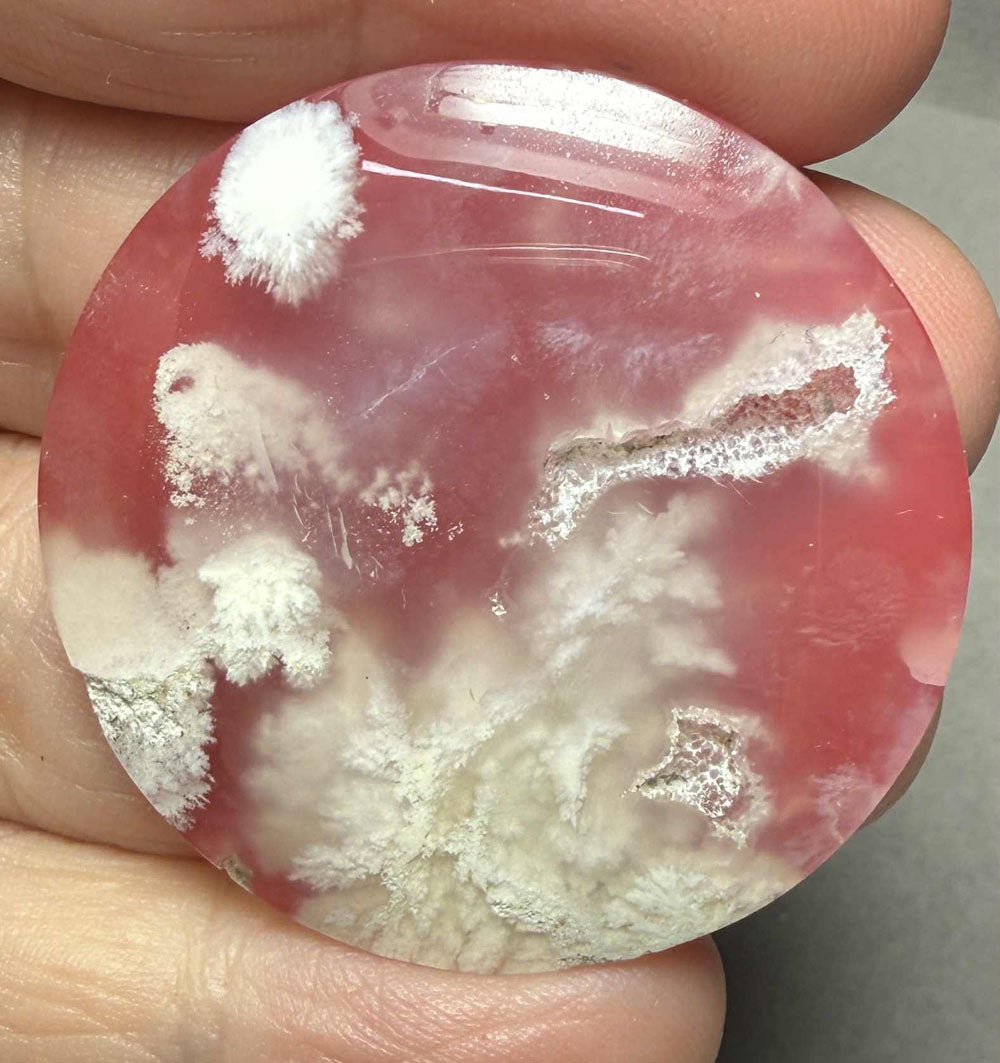
Round 38x38mm Indonesian Plume Agate Doublet Cabochon 87

1
/
of
1
Round 38x38mm Indonesian Plume Agate Doublet Cabochon 87
Round 38x38mm Indonesian Plume Agate Doublet Cabochon 87
Regular price
£12.00 GBP
Regular price
£0.00 GBP
Sale price
£12.00 GBP
Taxes included.
Shipping calculated at checkout.
Quantity
Couldn't load pickup availability
Size is approx: Length 38.1 mm Width 37.9 mm Depth 7.4 mm
The Cabochon weighs 15.2 gms
You will receive the Cabochon pictured.
A genuine Gemstone Cabochon suitable for setting, wire wrapping and all other forms of jewellery making.
Share